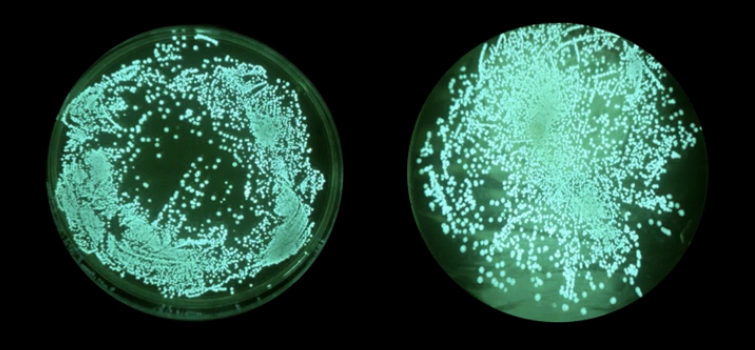

作者:@太空生物学·黄媂
假如你有机会乘坐潜水器下潜到伸手不见五指的深海中,就可以看到一些发光的水母。随着下潜深度的增加,你将会看到更多各种各样形状怪异发光的鱼类,虾类,微生物浮游类等一系列发光生物。
全球一共有70多种,会发光的真菌类蘑菇, 如果你有机会看到这些发光的蘑菇,一定会觉得很惊讶。 目前自然界中一共有2000多个萤火虫的品种,存在于我国的品种就有150多个。
我生活的城市以前萤火虫数量是很多的,晚上我们几个小伙伴会去阳江市第六中学附近的船厂抓一些来玩,十几年过去了现在看不到它们的踪影了。
小时候爸爸带着我和我的孪生姐姐去云南的一个山区游玩, 到了晚上整个山谷都是一闪一闪发光的萤火虫,许多萤火虫围绕着我们盘旋,仿佛身处仙境般一样。
自然界的动物类和真菌类有一些会发光,并不存在自身会发光的植物,那么电影《阿凡达》中的发光植物现实中有可能会出现吗?今天为大家科普一下——中国第一株自主发光的植物以及如何通过基因编辑让植物自身发光。

载体转化
在显微镜下观看植物的细胞,能清楚看到紫色的细胞核被绿色的叶绿体包围着,一个植物细胞通常只有一个细胞核,而叶绿体这种微小的组织则有上百个。当植物细胞核通过基因转化技术注入了在萤火虫身上提取到的荧光素酶基因和荧光蛋白基因之后,植物便有了愈伤组织,也就是长出了植株。
虽然荧光素酶基因和荧光蛋白基因这两个外源基因在植物细胞中能够产生了发光现象,但是散发出来的光度是极其微弱的,这种光度只能通过灵敏度较强的检测仪器才能检测到这两个微小外源基因所散发出的光。
造成植物不能发出强烈光的根本原因就是:植物中含有的荧光素酶基因和荧光蛋白基因数量太少了,这两个外源基因所发出的光自然也会跟着减少。
要想让植物细胞存在大量的荧光素酶基因和萤光蛋白基因,就只能在细胞的叶绿体基因中注入大量的荧光素酶基因和荧光蛋白基因,让它们完全发挥作用并且有显著的发光效果,这种注入基因的技术「叶绿体基因转化」。
图解:植物细胞结构示意图
叶绿体基因转化
对植物采用「叶绿体基因转化」的主要目的就是能够实现每一个叶绿体基因中都含有荧光素酶基因和荧光蛋白基因,一个植物细胞中有上百个叶绿体,也就是一个植物细胞里要含有上百个荧光素酶基因和上百个荧光蛋白基因。
「叶绿体基因转化」技术的缺点就是,无论在操作上或者是转化的层面上都是很难攻克的,从转化到成功花费的时间也比较长。
通过「叶绿体基因转化」将荧光素酶基因和荧光蛋白基因注入到植物细胞的叶绿体基因中,培育出来的植物就能够让植物发光了吗?
显然事情并没有这么简单。
萤火虫的发光元件包括有荧光素酶和荧光蛋白,发光的底物是荧光素。萤火虫发光的原理是发光底物荧光素要在空气和荧光素酶的共同催化作用下才会产生发光反应,然后释放出光。
图解:萤火虫发光原理图
举例说明:
小时候把萤火虫装在瓶子里,关上灯就能看到它们集体发光的美景,过了一段时间之后萤火虫发光的亮度就会有明显下降的趋势,甚至有一些已经驾鹤西去了,或者有一些已经奄奄一息几乎也要驾鹤西去了。
这是因为把萤火虫装在瓶子里阻断了荧光素酶基因中的荧光素与氧气相互之间的催化作用,导致荧光素没有发挥作用,因此就不能散放出光。
从上面的例子可以认识到虽然植物细胞中的叶绿体基因已经含有了荧光素酶基因,但是作为发光底物的荧光素基因只有一小部分被叶绿体基因吸收了,叶绿体通过自然吸收得到能够发生发光反应的荧光素基因并不多,与氧气产生催化作用的荧光素基因少了,植物发光的亮度自然就不会强。
即使注入大量的荧光素基因还是不能够让植物发出强光的,因为采用「叶绿体基因转化」注入的基因能够被叶绿体所吸收的数量实在是太少了,要让植物散发出强光,就要有更优越的发光基因。
高强度的基因转化
海洋中那些发光的微生物组成的发光系统,从宏观的层面上看,微生物的发光基因系统集合在一起,它们的发光基因系统共同营造出照亮一大片海域的美景。从微观的层面来看,每一个发光的亮点代表的是微生物身体之中的每一个细胞都在发光,微生物细胞中的荧光素酶基因和底物荧光素基因发光的机制是不需要借助外界的任何催化,自给自足,通过自身就能够自主发光,只要这些微生物的状况越佳,发光的亮度就越明显。
既然微生物可以自主发光,那么通过转化它们的基因是否可实现植物发光?
完全是可以的。
把在微生物细胞中提取到的荧光素酶基因和荧光素基因注入到大肠杆菌中,经过一段时间的培养,荧光素酶基因和荧光素基因能够在大肠杆菌中发挥出应有的作用,大肠杆菌像萤火虫那样有了明显的发光效果。
图解:发光的大肠杆菌
在不破坏叶绿体基因中的任何一个碱基的情况下,对叶绿体进行向高强度植物转化,也就是用基因枪对叶绿体基因进行物理轰击,将培养好的发光大肠杆菌注入到叶绿体基因组中相应的位置上,经过100天的时间叶绿体基因就有了明显的愈伤组织,也就是在伤口表面新生的组织——植株。
虽然物理轰击后的叶绿体基因长出了植株,但是并非每一个植株都会发光的,有些植株发出的光度很强,有些植株发出的光度很弱,有些植株根本就不会发光,甚至有些植株发光之后就不再发光了。
总结一系列问题之后,解决问题的突破口在于:只要检测出叶绿体基因中哪一些基因发光的含量较高,哪一些基因发光的含量较低,筛选出发光含量较低的基因,保留那些发光的含量较高的基因并注入到植物之中。
解决于以上的问题之后,我国于2017年培育出一株可持续发光,光亮度不会衰减的植物——「中国第一株自主发光植物」,这个科研成果用了5年的时间来完成,这株我国第一代的夜光植物不仅是我国每一次成功培育出真正的夜光植物,同时也填补了我国在相关技术以及科研方面的空白之处。
图解:中国第一株自主发光植物——本氏烟草
科学大爆发
科学除了要有勇于创新的想法,还要有永不放弃的毅力。过去通过生物工程培育出的“发光”植物,并不是真正会自主“发光”的植物,例如:
①在蓝紫光的照射下佩戴特定眼镜看到的荧光植物、
②注入了荧光素底物短暂发光并且发出的夜光肉眼不可见的植物、
③表面喷洒荧光粉实现短暂散发夜光的植物、
以上3种情况算不上是真正的夜光植物,真正的夜光植物是不需要借助外界的任何因素来达到发光效果的。
发光基因注入难吗?
获取一个微生物的发光基因难度是非常大的,不能在操作上有一丢丢过失,否则就无法保证基因的完整性。注入一个发光基因到叶绿体基因中,更是难上加难。通常一个植物的细胞只有一套核基因组,但是一个植物细胞中却含有上百个叶绿体,并且每个叶绿体里有上百套叶绿体基因组拷贝,正所谓“小结构,大组织”。复杂的配对让每个植物细胞中存在着近万个叶绿体基因组拷贝,所以将提取到的发光基因注入到指定的叶绿体基因组位置上,是一件非常困难的事情。
中国第一株自主发光植物后续
中国第一株发光植物,也就是中国和第一代发光植物,这株植物的载体是本氏烟草,采用烟草来作为载体主要有两个原因:
特点一:培育周期短
只要供给它些少的水份、阳光、和氧气就会在短时间内快速成长。
特点二:发光效果显著
只要供给它适宜的温度发光基因就会有显著的发光效果。
这株烟草植物在日常的光照下与普通的植物没什么分别,当关上灯时它在黑暗的暗室中就会发出暗淡的微光,随着关灯的时间越久,烟草发光的光度就会越明亮。
虽然这株第一代的发光植物是分不清白昼与黑夜,每时每刻都在散发着光,只要它身处黑暗之中我们就能够看到它发光时的面貌,然而这株发光植物是我国第一次培育发光植物成功的案例,同时也体现出我国在相关领域等一些技术层面上的不足之处。
对于让植物能分清白昼和夜晚,只在黑暗时才发光,处于有光照时则不发光并将能量存储起来,待面对黑暗时则散发出强烈的光,目前的发光植物并不能发挥出这样的特性,科研人员正在努力让植物做到这点,让我们拭目以待科研人员的研究结果。
@太空生物学·总结——自然界生物进化的必然之路
发光植物的问世,有反对的声音,也有支持的声音。
发光植物是科学的创新,代表的是科学的进步,通过基因编辑培育出来的发光植物无论对人或是环境都是无害的,发光植物赋予了传统观赏植物的新定义——发光的植物。
那些反对夜光植物的人总是说:“培育出自主发光的植物,这是违反了自然界的进化论,既然大自然选择了不进化出自主发光的植物,我们何必非要创造出自主发光的植物。”
我本人不是这么认为的,我反而是支持创造自主发光植物的,因为在自然界的生物自主发光是一个十分常见的现象,种类也是五花八门,比如:
甲壳类·赫氏海萤、鱼类·琵琶鱼、多足类·发光蜈蚣、昆虫类·萤火虫、外肛动物类·棘膜苔虫、原生动物类·腰鞭水虫、环节动物类·发光蚯蚓、软体动物类·发光蜗牛、纽形动物类·燐纽虫、原索动物类· 纽鳃樽、节肢动物类·蕈蚊、腔肠动物类·仙游水母、脊索动物类·守宫、真菌类·荧光脐菇、
全球会自主发光的生物一共有700多种,当中有动物、微生物和真菌,唯独没有植物,会自主发光的植物占有的种数为0。自然界中并不存在会自主发光的植物,事实上目前我们所看到的发光植物,例如:“夜皇后花”、“灯笼树”、“水晶兰”、“蜡烛树”等等。其实它们并不是真正自主发光的,它们之所以会发光是因为植物当中含有的磷质会释放出磷化氢,这种气体在空气中的燃点一般在38℃左右,这是植物产生的一种自燃现象,会散发出淡蓝色的光,因此看起来就好像植物本身在发光一样,并非是植物自主发出的光。
图解:冥界之花——水晶兰
生物发光的意义
萤火虫之所以发光,是因为它们在求偶时为了吸引异性。荧光脐菇之所以发光,是为了吸引昆虫来传播孢子繁衍后代。仙游水母之所以发光,是为了把猎物吸引过来。
对于生物而言,发光都是具有一定吸引力的,在自然界中很多生物都在向着发光的方向进化,并且有些生物具有一定的趋光性,例如活细胞体内的大分子,在一些自然的条件下是会散发出光的。在这个多样性的生物大爆发年代,每一个细胞基因都有它存在的意义,存在即合理,因此动物的发光基因能够和植物的叶绿体基因互相溶合,会成为自然界生物进化的必然之路。
珍惜
现在的地球在光污染和水污染的影响下,小时候常见的萤火虫渐渐淡出了我们的视野,它们存在的数量已不多了,为了我们的下一代能亲眼目睹萤火虫散发出的绿光,假如那一天你在路上看到萤火虫,请好好地善待它——眼见手不动。